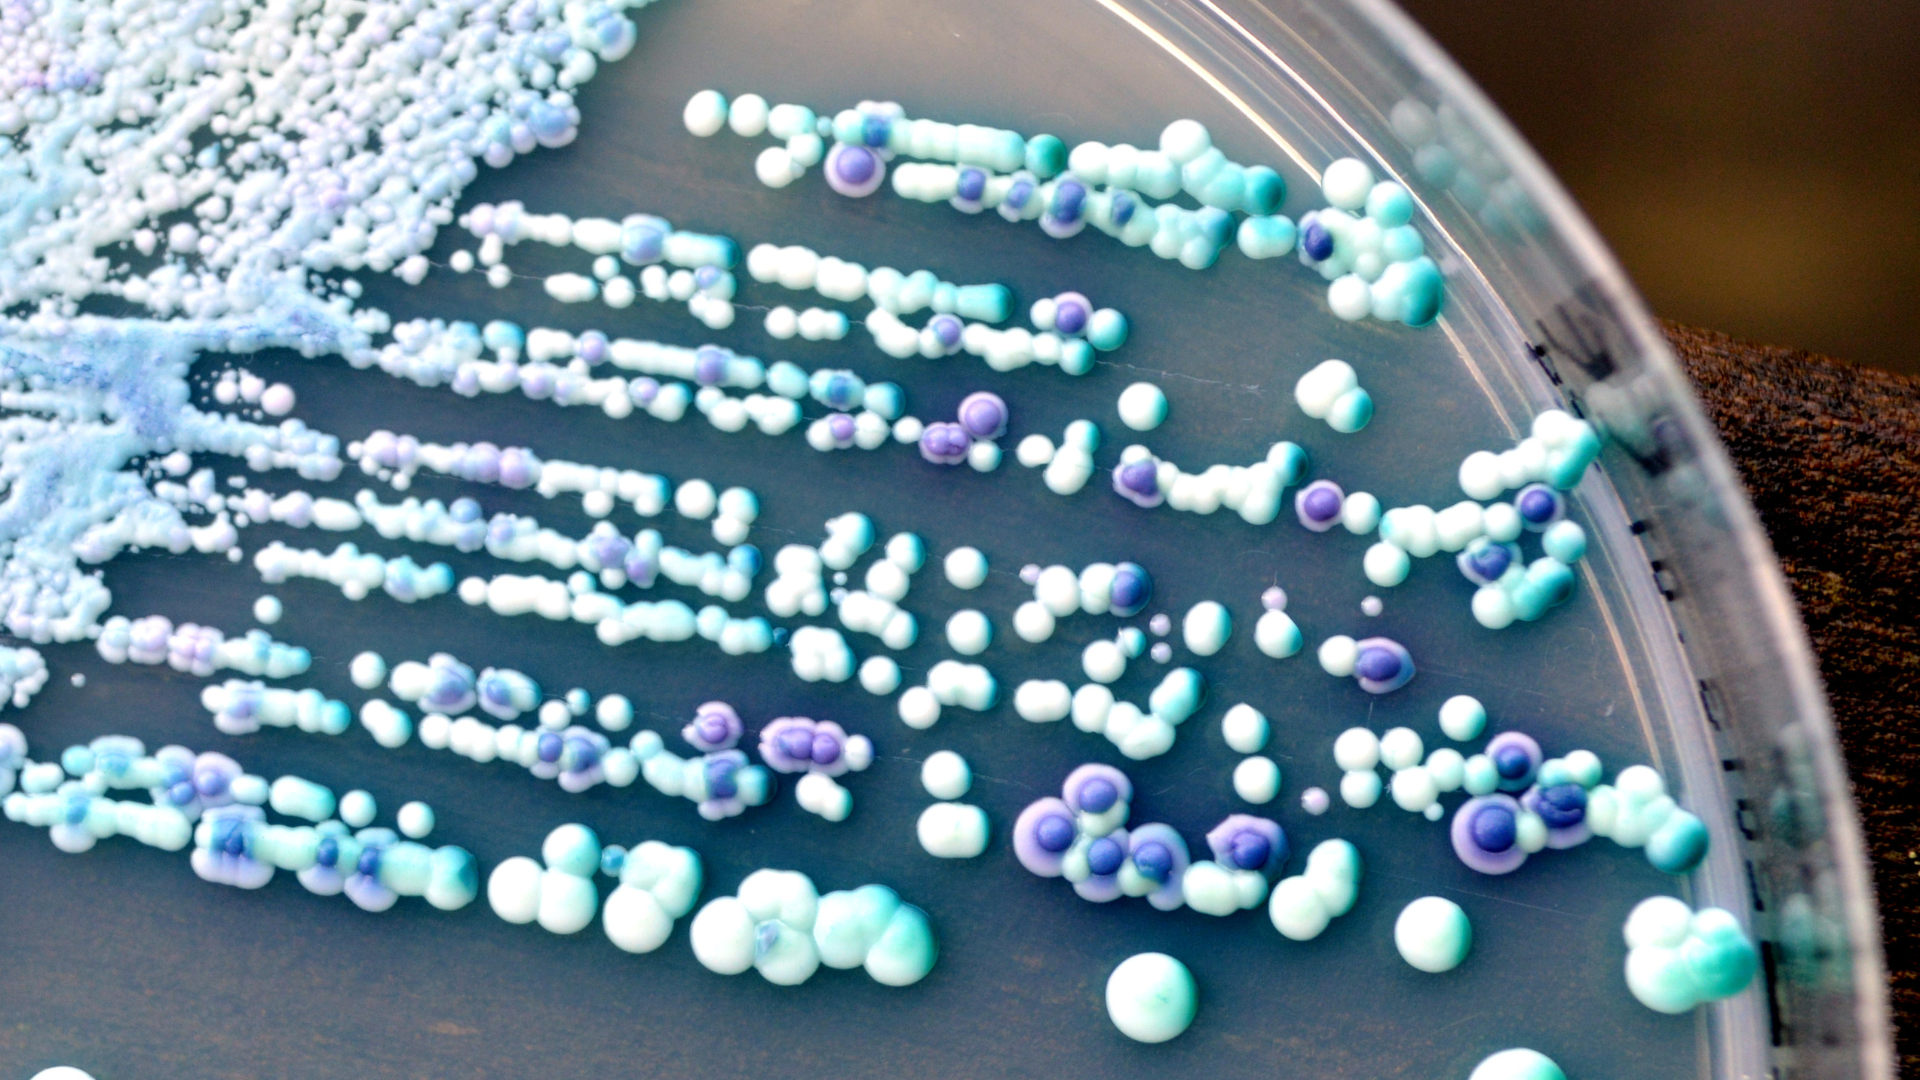
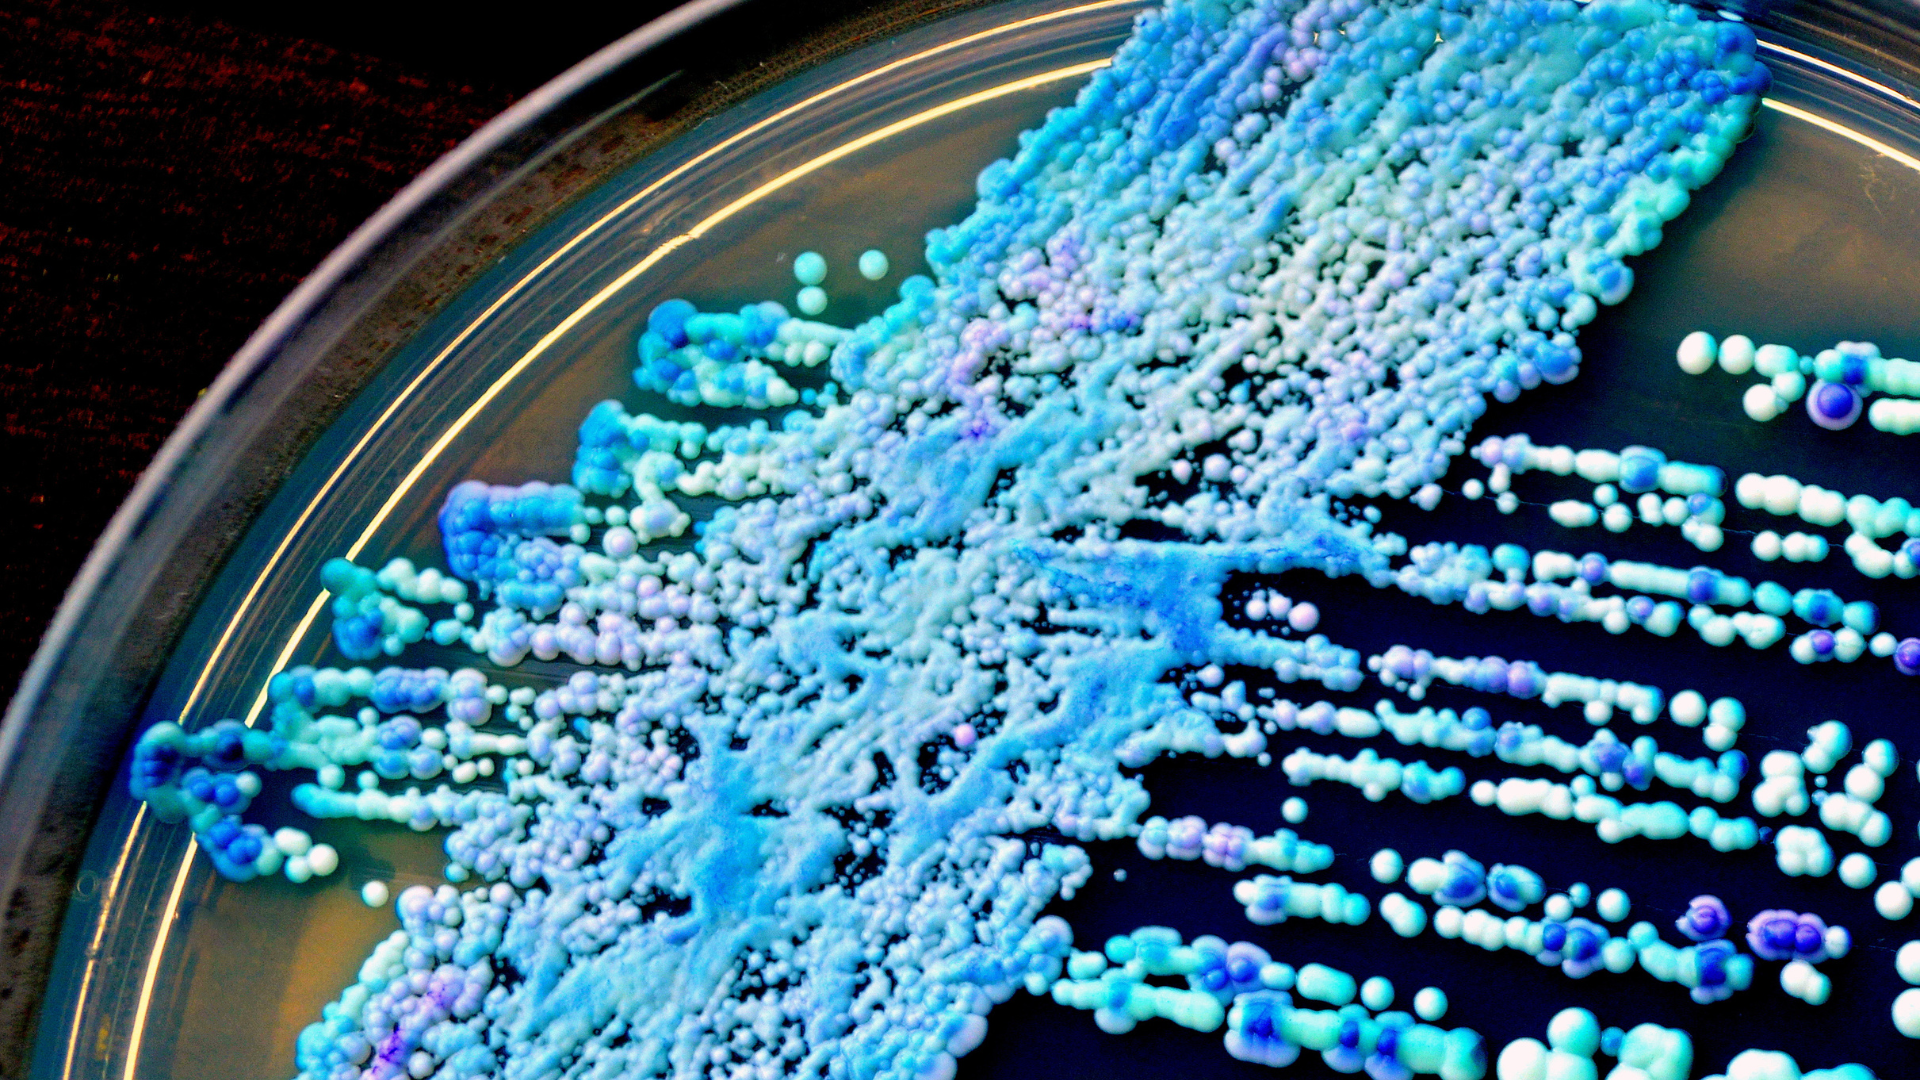

Candida Auris: Understanding the Threat and Harnessing UV-C Technology
In the ever-evolving landscape of infectious diseases, Candida Auris has emerged as dangerous and misunderstood. This drug-resistant fungus first surfaced in 2009, causing infections in healthcare settings. Originating in Asia, Candida Auris has since spread globally, posing a significant threat to public health. Unlike other members of the Candida family, Candida Auris exhibits a concerning ability to cause outbreaks in healthcare facilities, leading to severe bloodstream infections, ear infections, and wound infections. The heightened resistance of this fungus to common antifungal medications makes it a public health challenge.
How Does Candida Auris Affect People and the Healthcare Industry?
Candida Auris poses a threat to individuals and the healthcare industry. Its ability to persist on surfaces for extended periods makes it challenging to eradicate from healthcare environments, leading to recurrent outbreaks. The fungus is particularly adept at causing bloodstream infections, posing a serious risk to vulnerable patient populations, and leading to a risk of a HAI. The healthcare industry faces challenges in managing infections due to Candida Auris’s resistance to multiple antifungal drugs, limiting treatment options and the need for rigorous infection control measures.
Candida Auris, a relatively recent addition to the realm of infectious diseases, possesses strengths that set it apart from other fungal pathogens. These characteristics contribute to its status as a challenging fungus in healthcare settings.
– Persistence on Surfaces:
One of Candida Auris’s strengths is its ability to persist on surfaces for extended periods. Unlike many other fungi, which may have a limited lifespan outside a host, Candida Auris can survive on various surfaces such as medical equipment, bed rails, and other healthcare-related environments. This persistence contributes significantly to the challenges in eradicating the fungus from healthcare settings, making it a recurring concern for nosocomial infections.
– Resistance to Antifungal Medications:
Candida Auris has exhibited an alarming resistance to multiple classes of antifungal medications. This resistance poses a clinical challenge, as the commonly used antifungal drugs may prove ineffective in treating infections caused by this fungus. The development of resistance not only limits treatment options but also highlights the need for alternative therapeutic approaches and stringent infection control measures to prevent its spread.
– Capacity for Nosocomial Outbreaks:
Candida Auris is particularly adept at causing outbreaks within healthcare facilities. Its capacity to colonize and infect patients, coupled with its ability to persist in the environment, contributes to the occurrence of nosocomial outbreaks. The fungus can spread from patient to patient, and its resilience on surfaces makes it a persistent threat, necessitating heightened infection prevention and control measures to curb its transmission within healthcare settings.
– Challenges in Identification:
Identifying Candida Auris poses a unique challenge due to its close resemblance to other Candida species. Conventional identification methods may not readily distinguish Candida Auris from other, less problematic Candida species, leading to potential delays in diagnosis and intervention. The ability of the fungus to go undetected highlights the challenges in implementing timely and effective control measures.
Understanding these unique strengths of Candida Auris is crucial for developing targeted strategies in combating its spread and implementing effective infection control measures. As researchers and healthcare professionals continue to investigate and address this emerging threat, innovative approaches, including advanced diagnostics and environmental disinfection methods, are imperative for mitigating the impact of Candida Auris on public health.
Vulnerabilities of Candida Auris:
Despite its strengths, Candida Auris has vulnerabilities that can be leveraged for effective control. The fungus is susceptible to certain disinfectants, emphasizing the importance of thorough environmental cleaning and disinfection practices in healthcare facilities. Early detection and intervention are critical in managing and controlling outbreaks, underlining the significance of surveillance and diagnostic measures.
In the ongoing battle against Candida Auris, UV-C technology stands out as a safeguard, offering a powerful and effective solution. UV-C light, characterized by its short wavelength, plays a pivotal role in disrupting the genetic material of microorganisms, including the resilient Candida Auris. This disruption renders the fungus unable to reproduce or cause infections, marking UV-C as an invaluable tool for disinfecting surfaces and air in healthcare settings where Candida Auris may persist. The efficacy of UV-C technology lies in its ability to provide chemical-free, swift, and highly efficient disinfection.
Properties of UV-C Technology Against Candida Auris:
– Effective Disinfection:
UV-C light proves highly effective in neutralizing Candida Auris both on surfaces and in the air. The short wavelength of UV-C ensures thorough and rapid disinfection, reducing the risk of transmission within healthcare environments. This property is particularly crucial in mitigating the persistence of Candida Auris, contributing to enhanced infection control measures.
– Chemical-Free:
A standout feature of UV-C technology is its chemical-free nature. Unlike traditional disinfection methods that may involve the use of chemicals, UV-C relies on the power of light to achieve germicidal effects. This minimizes the risk of creating resistant strains of microorganisms, contributing to the long-term sustainability of infection control efforts. Additionally, the chemical-free aspect ensures environmental safety, aligning with the broader goal of promoting eco-friendly practices within healthcare settings.
– Fast and Efficient:
UV-C disinfection is characterized by its swiftness and efficiency. The technology allows for quick turnaround times in healthcare environments, minimizing disruptions to operational processes. The rapid disinfection capability is especially advantageous in settings where timely and thorough decontamination is essential for maintaining a safe and sterile environment.
– Non-Selective:
UV-C technology is non-selective in its action, targeting a broad spectrum of microorganisms, including Candida Auris. This comprehensive approach makes UV-C a versatile solution for infection control. By addressing a wide range of pathogens, UV-C technology contributes to a more resilient and robust healthcare environment.
As the healthcare industry continues to grapple with the challenges posed by Candida Auris, the integration of UV-C technology, with its inherent properties, presents a proactive and effective means of combating the persistence and transmission of this resilient fungus. The chemical-free, rapid, and non-selective nature of UV-C technology positions it as a cornerstone in the ongoing efforts to enhance infection control measures and ensure the safety of healthcare environments.
In the face of the rising threat posed by Candida Auris, a comprehensive and strategic approach is essential. UV-C technology, with its potent disinfection properties, stands as a beacon of hope in healthcare settings. Paired with the precision of Intellego dosimeters, the fight against Candida Auris becomes not just a battle but a data-driven campaign to safeguard public health. As the healthcare industry continues to grapple with emerging challenges, UV-C technology and dosimetry innovation offer a promising path forward in ensuring cleanliness, safety, and infection control.
The Intellego Dosimeter Solution
The unique strengths of Candida Auris, including its persistence on surfaces and resistance to antifungal medications, highlight the need for innovative approaches to infection control. UV-C technology, with its chemical-free, swift, and non-selective properties, proves to be a beacon of hope in healthcare settings where Candida Auris may persist. Paired with the precision of our dosimeters, the fight against Candida Auris becomes a data-driven campaign to safeguard public health.
Intellego dosimeters play a crucial role in this strategic approach, providing real-time, measurable data to accurately verify the effectiveness of UV-C systems. By ensuring UV-C exposure levels are optimized for maximum disinfection without compromising safety, Intellego dosimeters contribute to creating a more resilient and robust healthcare environment. This partnership between UV-C technology and Intellego dosimeters underscores a commitment to data-driven infection control, offering a comprehensive solution to the evolving challenges in healthcare settings.
Our team at Intellego Technologies are constantly evaluating the healthcare landscape, looking for solutions and answers where our dosimeters can make a difference. If you are interested in learning more, please reach out to our experts today and we can have a conversation.
About Intellego Technologies AB
Intellego Technologies is a research and development company, headquartered in Solna, Sweden. Founded in 2011, Intellego has grown to become the global leader in colorimetric indicators that are utilized worldwide to visually validate the dose of ultraviolet irradiation delivered to surfaces. Through its patented photochromic technology, Intellego manufactures standard and customized indicators that make the benefits of ultraviolet light visible and promotes the safe, effective and efficient use of UV applications. Intellego’s products support better outcomes with ultraviolet devices in healthcare, food and beverage manufacturing, environmental services, and more. For more information about Intellego, visit Intellego-Technologies.com. For more information on Intellego’s line of colorimetric indicators, visit UVCdosimeters.com.

